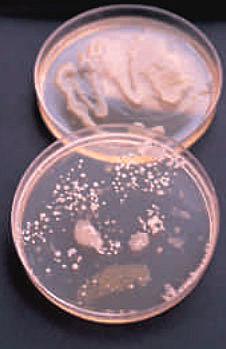
Hechos importantes de la Fitopatologia

-
Micheli observo por primera vez las partículas de polvo de un hongo
-
Antonio Van estudio la anatomía de las plantas. los hongos, las bacterias y los microorganismos.
-
Prevos demostró que el carbón que cubre el trigo es ocasionado por un hongo
-
La devastadora destrucción de cultivos en Irlanda ocasionada por Phitopthora infestans lo que ocasiono la muerte por hambre de muchas personas
-
Bary demostró experimentalmente que el Phytopthora infestans fue el causante de la enfermedad en Irlanda
-
Bretel desarrollo técnicas de cultivo de microorganismos en cultivos puros.
-
Rober koch etiología de la tuberculosis por medio de un experimento de la enfermedad infecciosa y bacteriana.
-
Adolph Mayer comprobó el mosaico del tabaco, no transmitiéndose en el jugo de las plantas enfermas sino en una bacteria.
-
En este año se hizo el primer cultivo de tejidos vegetales.
-
Stewart aplico la embriogénesis y demostró que podían incluirse cultivos de zanahorias por suspensión para formar embriones.